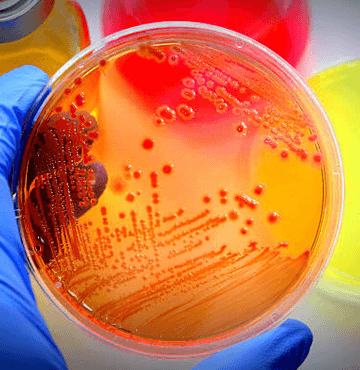
About

ISCSG is an all India Registered Association having members from various part of India. Every year one International confrence is being organised by ISCSG along with a
combined meeting being held with Annual National Confrences of Indian Orthopaedic Rheumatology association. A specialty session of ISCSG being conducted in this where all
research work related to regenerative science is discussed and promoted.
The official website of ISCSG is www.iscsg.com Various writeup of its members are regularly being updated and can be visited on official website
www.orthopaedicrheumatology.com
Apley Orthopaedic Centre
1/9 Vastu Khand Gomtinagar
Lucknow, Uttar Pradesh - INDIA
Email Id: manishvenus@rediffmail.com
Phone No: 9415167349
Prof. Orthopaedics President, Emeritus Indian Orthopaedic Rheumatology Association, President Indian Stem Cell Study Group Association, Former Consultant Sanjay Gandhi Post Graduate Institute-Lucknow, Editor in Chief International Journal of Orthopaedic Rheumatology, Former VP Indian Foot Ankle Society, Fellow International Medical Science Academy.
Visit:
www.orthopaedicrheumatology.com
ISCSG Gold Medal Criteria News Letter ISCSG Previous Gold Medals International Journal of Orthopaedic Rheumatology ISCSGCON 2023 (Nagpur) AIIMS Patna & Indian Stem Cell Study Group Association Conclave 2024 ISCSG Member List 2025 ISCSGCON HYDERABAD 2026 REGEN MED CONCLAVE - 2024 Late Dr. Sankaranarayanan 8th Stem Cell and Cancer Conference AIIMS Delhi Regenerative Medicine and Stem Cell Therapy CME Invitation-1
Regenerative science holds a positive future in medical conditions which faces lot of challenges in presently available stem cell transitional research and application. Stem cells are receiving a great deal of scientific attention and one of the many reasons for this attention is their ability to regenerate various tissues and thus can be used in various medical conditions For many years, bone marrow-derived stem cells (BSCs) are the primary source of stem cells for tissue engineering applications (Caplan, 1991; Pittenger et al., 1999; Caplan, 2007). In the field of regenerative medicine, basic research and preclinical studies have been conducted to overcome clinical shortcomings with the use of mesenchymal stem cells (MSCs). Human postnatal bone marrow contains mesenchymal stem cells (MSCs) capable of differentiating into multiple mesenchymal tissues such as bone, adipose, cartilage, and myelosupportive stroma.). Progeniter cells application(autologous minimally manipulated MNCs) is the most important strategy for various medical ,neurological and orthopaedic conditions.
ISCSG’s 3rd International Conference on Stem cell and Regenerative Medicine 2019 www.iscsg2019.com
Disclaimer :
STEM CELL RESEARCH HAS POTENTIAL TO TREAT MANY DIFFERENT DISEASES BUT MOST STEM CELL RESEARCH IS STILL AT THE LABORATORY/EXPERIMENTAL STAGE OR IN FORM
OF EARLY CLINICAL TRIALS. ONLY HAEMATOPOETIC STEM CELL THERAPY IS A PROVEN TREATMENT .













































































Dr. Asim Gupta
Dr. Avinash Gandi
Prof. Bishnu Prasad
Dr. Girinivisan Chellamuthu
Dr. Karun Jain
Dr. Mahendra Kudchadkar
Dr. PL Srinivas
Dr. Marco Traub (Swit)
Dr. Sayan Basu (India)
Dr. Charan Ganta (USA)
Dr. Sairam (USA)
Dr.R.Secunda (Chair)
Dr.Avinash Gandi (Co-Chair)
Prof. Dr.Manish Khanna (Chair)
Dr.V.R.Ravi (Co-Chair)
Dr. Vasan SS (Chair)
Prof. Dr. M. Natesh Pabhu (Co-Chair)
Dr. Nayana Patel (Chair)
Prof. Dr. Deepti Srivastava (Co-Chair)
Prof. Shilpa Sharma (Chair)
Dr. Sagar Jawale (Co-Chair)
Prof. Dr. J. Gnanaseivan (Chair)
Dr. Gowri Priya (Co-Chair)









To become a member Kindly Click here
